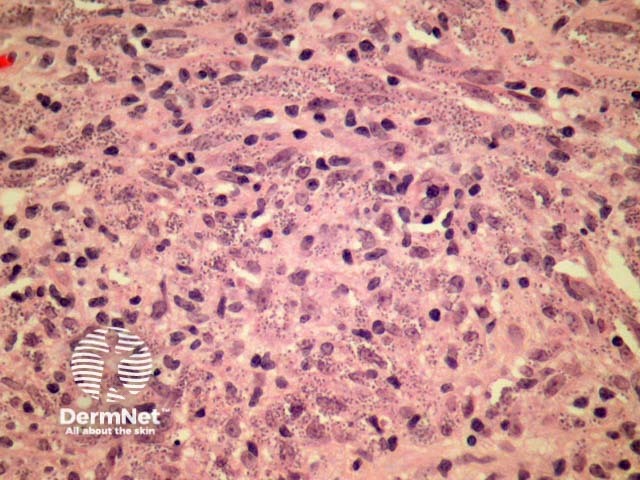
Figure 2
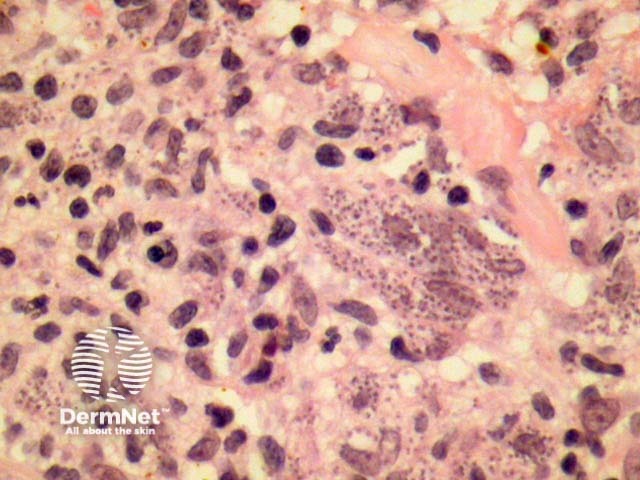
Figure 3

Main menu
Common skin conditions
NEWS
Join DermNet PRO
Read more
Quick links
Infestations Diagnosis and testing
Author: Assoc Prof Patrick Emanuel, Dermatopathologist, Auckland, New Zealand, 2013.
Introduction Histology Special stains Differential diagnoses
Leishmania is an organism related to the trypanosomes. The inflammatory disease caused by the organism may involve skin and mucous membranes, as well as internal organs. The organism's lifecycle contains a flagellate phase (promastigote) while living within the vector, and a phase when the flagellum is retracted (amastigote) which is the stage seen in human infection and visualized in tissue sections or smear preparations.
There are three basic types of cutaneous leishmaniasis: cutaneous leishmaniasis (acute and chronic), mucocutaneous leishmaniasis, and disseminated anergic cutaneous leishmaniasis.
Depending in the clinical type and stage, in leishmaniasis, the epidermis may be either ulcerated with marked secondary changes and epidermal reaction, or alternatively the epidermis may be quite unremarkable and overlying a dense dermal infiltrate (figure 1). The infiltrate is typically dense and contains predominantly histiocytes, lymphocytes and plasma cells (figure 2). Other acute inflammatory cells are usually difficult to find unless there is ulceration and secondary changes. The infiltrate may surround neurovascular bundles akin to lepromatous leprosy.
The leishmania organisms are typically easy to visualise on routine H-E sections during the earlier stages of the disease and – like lepromatous leprosy – may be difficult to find late in the disease where there is a resolving granulomatous and sclerotic inflammatory pattern. In early stages of leishmaniasis, numerous amastigotes typically distend histiocytes (figure 3) and impart quite a characteristic diagnostic morphology.

Figure 1
Figure 2
Figure 3
The leishmania organisms are typically intensely positive with Giemsa stain where they stain blue on paraffin embedded sections. Skin or other organ smears can also demonstrate the organism with Giemsa stain. In difficult cases, or for precise organism characterisation molecular techniques such as polymerase chain reaction (PCR) can be applied.
Histoplasmosis — The organisms are of a similar size to leishmania but stain readily with silver stains, show narrow-based budding, and a peri-organism halo.
Granulomatous disease – The late granulomatous stages of leishmaniasis may resemble sarcoidosis or other granulomatous diseases. PCR based methods may aid in the diagnosis when the organisms are scarce or impossible to visualise with haematoxylin and eosin (H-E) and Giemsa stains